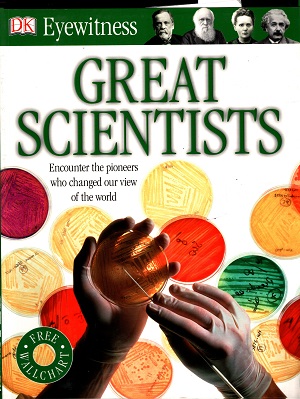
Great Scientists

Baatighar
|
Publisher |
|
|
ISBN |
9781405373234 |
|
Language |
English (US) |
|
Country |
India |
|
Format |
Paperback |
|
Pages |
72 |
No Specifications